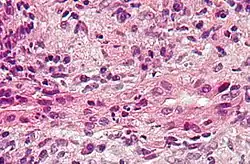

التهاب الأقنية الصفراوية الأولي
تشمع المرارة الأولي (بالإنجليزية: Primary biliary cirrhosis).تعرف أختصاراً(PBC) هو حالة مرضية تنتج عن ضرر في مسالك المرارة الموجودة الكبد، إلى درجة لا يستطيع فيها الكبد إفراز سائل المرارة وارساله إلى الجهاز الهضمي. مما يسبب في تراكم للمواد السامة في الجسم بشكل عام،[1][2] وفي الكبد بشكل خاص، ومن الممكن ان يؤدي لتندب الكبد أو حتى تشمعه وتصبح صعبة العلاج .[3]
| تشمع المرارة الأولي | |
|---|---|
![]() صورة مجهرية من التشمع الصفراوي الأولي" تظهر التهاب القناة الصفراوية وإصابتها. صبغة H&E. صورة مجهرية من التشمع الصفراوي الأولي" تظهر التهاب القناة الصفراوية وإصابتها. صبغة H&E. | |
| معلومات عامة | |
| الاختصاص | طب الجهاز الهضمي |
| من أنواع | تشمع الكبد ، ومرض الجهاز الهضمي بالمناعة الذاتية |
| الإدارة | |
| أدوية | |
السبب
حتى الان لا يعرف السبب الرئيسي في تشمع المرارة الأولي حيث ما زال موضوع نقاش بين الكثير من المختصين. ولكن بعض الباحثين يقولون بأن السبب ناتج عن عملية يقوم خلالها جهاز المناعة بمهاجمة خلايا الجسم السليمة (Autoimmune) عن طريق الخطا، الا ان لهذا المرض أيضا مؤثرات وراثية وبيئية.[4][5]
الأعراض
تختلف الاعراض من حالة إلى اخرى حيث تكون في بداية المرض مميزة ب: -التعب والضعف العام. -حكة وخاصة في منطقة القدمين والرجلين والظهر . -جفاف في العينين . أما عند اشتداد الحالة تتميز الأعراض ب: -اليرقان (الإصفرار). - اورام دهنية – كوليسترولية. -وذمة(انتفاخ في القدمين). -ظهور الدوالي. -تشمع الكبد. -تخللخل العظام(هشاشة العظام). -ازدياد احتمالات الإصابة بسرطان الكبد. -كما لدى المصابين بتشمع المرارة، يظهر ازدياد بالإصابة بامراض اخرى مثل تصلب الجلد من نوع CREST، التهاب المفاصل الروماتيزمي، متلازمة رينو (Raynaud) واضطرابات بالغدة الدرقية. بالإضافة إلى اضطرابات ذهنية، وخصوصا انخفاض القدرة على التركيز وتراجع الذاكرة.
الوباء

.
من الناحية "الوبائية"، يظهر المرض في 90% من الحالات لدى النساء. غالبية هؤلاء النساء هن بجيل 35 – 60 عاما.
التشخيص
على الأغلب يكون تشخيص الإصابة بالمرض حتى قبل ظهور الاعراض، وذلك نظرا لان فحص دم عادي يكشف عن ارتفاع مستوى انزيمات كبدية معينة في الدم. بعد ذلك يتم اجراء فحوص الامواج فوق الصوتية (الاولتراساوند) للكبد من اجل التاكد من عدم وجود اسباب اخرى لارتفاع انزيمات الكبد. كذلك، يتسم هذا المرض بظهور مضادات ذاتية من نوع Anti - mitochondrial antibodies. اما التشخيص النهائي، فعادة ما يتم من خلال اخذ عينة من انسجة الكبد.
بالنسبة لاقارب المصاب بتشمع المرارة من الدرجة الاولى، يتم اجراء فحص المضادات الذاتية في مراحل مبكرة، وقبل ظهور ارتفاع مستويات انزيمات الكبد. بهذا الشكل، من الممكن فحص احتمالات ان يصاب هؤلاء بالمرض وحتى علاجهم بمرحلة مبكرة إذا اقتضى الامر.
العلاج
لا يوجد حالياً علاج شاف لحالة مرض تشمع المرارة الاولي ولكن يتم علاج الأعراض التي تصاحب الحالة نظرا لعدم وجود اي دواء قادر على شفاء هذا المرض، فان علاج تشمع المرارة الاولي يتمحور حول تاخير تفاقمه قدر الإمكان، إضافة للتخفيف من اعراضه ومنع مضاعفاته.وهنالك الكثير من الادوية التي تعمل على تخفيض مستويات الكوليسترول، منها "كوليستريمين" (cholestyramine)، و"كوليستيفول" (Colestipol)، والـ"ريفامبين" (Rifampin). كذلك، فان استخدام ادوية من العائلة "الافيونية" من الممكن ان يساعد بعض المرضى على مواجهة الحكة الشديدة، كما ان الفترة الاخيرة تشهد تجارب سريرية متقدمة على بعض انواع الادوية التي تمنع الشعور بالتعب والضعف. كذلك، هناك علاجات خاصة وظيفتها منع المضاعفات الناتجة عن ارتفاع ضغط الدم في وريد الباب الكبدي، تخلخل العظام، ونقص الفيتامينات الذائبة بالدهون. حمض الارسوديول (Ursodeoxycholic acid) - هذا الدواء يساعد على تفريغ سائل المرارة من الكبد، وثبت انه يطيل العمر. يستخدم كعلاج في المراحل الاولى من الإصابة بالمرض، غير انه لا يبقى فعالا في المراحل المتقدمة. من اعراض استخدام هذا الدواء الجانبية: ازدياد الوزن، فقدان الشعر والاسهال.
اليوم، هنالك الكثير من الادوية التي تتم تجربتها مخبريا وسريريا (Clinical trials)، والتي من الممكن ان تكون علاجات مستقبلية. عندما يتفاقم المرض ويخرج عن السيطرة، تصبح هنالك حاجة لزرع كبد. صحيح ان زرع كبد جديد يخلق تحسنا ويطيل العمر، الا ان هذا لا يمنع امكانية ان يعاود تشمع المرارة اصابة الكبد الجديد المزروع.
مراجع
- Hirschfield, GM (Jan 24, 2013). "The immunobiology and pathophysiology of primary biliary cirrhosis". Annual review of pathology. 8: 303–30. doi:10.1146/annurev-pathol-020712-164014. PMID 23347352. الوسيط
|CitationClass=تم تجاهله (مساعدة) - Dancygier, Henryk (2010). Clinical Hepatology Principles and Practice of. Springer. صفحات 895–. ISBN 978-3-642-04509-7. مؤرشف من الأصل في 15 مارس 2020. اطلع عليه بتاريخ 29 يونيو 2010. الوسيط
|CitationClass=تم تجاهله (مساعدة) - Saxena R, Theise N (February 2004). "Canals of Hering: recent insights and current knowledge". Semin. Liver Dis. 24 (1): 43–8. doi:10.1055/s-2004-823100. PMID 15085485. مؤرشف من الأصل في 06 نوفمبر 2018. الوسيط
|CitationClass=تم تجاهله (مساعدة) - Logan RF, Ferguson A, Finlayson ND, Weir DG (1978). "Primary biliary cirrhosis and coeliac disease: an association?". Lancet. 1 (8058): 230–3. doi:10.1016/S0140-6736(78)90480-4. PMID 74661. الوسيط
|CitationClass=تم تجاهله (مساعدة)صيانة CS1: أسماء متعددة: قائمة المؤلفون (link) - Volta U, Rodrigo L, Granito A; et al. (2002). "Celiac disease in autoimmune cholestatic liver disorders". Am. J. Gastroenterol. 97 (10): 2609–13. doi:10.1111/j.1572-0241.2002.06031.x. PMID 12385447. الوسيط
|CitationClass=تم تجاهله (مساعدة); Explicit use of et al. in:|مؤلف=(مساعدة)صيانة CS1: أسماء متعددة: قائمة المؤلفون (link)
وصلات إضافية
- Primary Biliary Cirrhosis page from the National Digestive Diseases Information Clearinghouse
- Primary Biliary Cirrhosis page from the American Liver Foundation
- PBCers.org — patients' organisation
- PBC-Society.ca — Canadian PBC patient and research support
- PBC Foundation UK
- UK PBC - UK PBC research
- بوابة طب
صور وملفات صوتية من كومنز